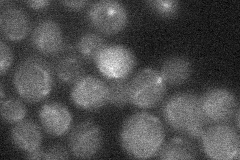
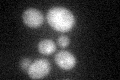

View description
Probable subtilisin-family protease with a role in formation of the dityrosine layer of spore walls; localizes to the spore wall and also the nuclear envelope and ER region in mature spores
Localization:
Intensity:
Fold change:
Significance:
-
C’ GFP library in SD

below threshold16.91 -
N' NOP1pr-GFP in SD

ER39.3325 -
N' TEF2pr-mCherry in SD

vacuole7.25625 -
N' NATIVEpr-GFP in SD
below threshold16.887 -
N' TEF2pr-VC and Cyto-VN in SD

#N/A0 -
C’ GFP library in SD+DTT
cytosol16.250.96No -
C’ GFP library in SD+H2O2

cytosol17.781.05No -
C’ GFP library in Starvation Media

cytosol14.980.88No -
C’ GFP library on the background of Pup2-DaMP

below threshold -
C’ GFP library on the background of CCT mutant

below threshold18.10721.0705No
